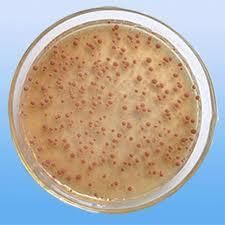
固氮細菌

分類
固氮細菌⑴自生固氮菌:指各種自由生活、能獨立固定大氣氮的原核生物,包括多種生理類型的種類,如化能異養、好氧性的固氮菌屬(Azotobacter)、化能異養、兼性厭氧的克雷伯氏菌屬(Klebsiella)和化能異養、專性厭氧的巴氏梭菌(Clostridium pasteurianum),光能自養、好氧性的念珠藍細菌屬(Nostoc)、光能異養、兼性厭氧的紅螺菌屬(Rhodospirillum)和光能自養、專性厭氧的著色菌屬(Chromatium)等。
⑵共生固氮菌:指必須與它種生物共生時才能固氮的原核微生物。包括與豆科植物共生結根瘤的根瘤菌屬(Rhizobium)、與非豆科植物共生結根瘤的弗蘭克氏菌屬(Frankia)放線菌以及與地衣共生的魚腥藍細菌屬(Anabaena)等。
⑶聯合固氮菌:指必須生活在植物根際、葉面或動物腸道等處才能固氮的原核生物。包括在熱帶植物根際固氮的固氮螺菌屬(Azospirillum)以及在葉面固氮的拜葉林克氏菌屬(Beijerinckia)等。所有的固氮菌都有固氮酶,在有氧障保護的嚴格厭氧微環境中進行固氮。生物固氮對全球生物圈的存在、繁榮與發展極端重要,對人類的生存和農業增產也有極其重要的作用。
保護
好氧固氮菌防止氧傷害其固氮酶的機制
固氮酶對氧極其敏感,因此固氮作用必須在嚴格的厭氧條件下進行。這對於厭氧固氮菌當然不成問題。但是大多數固氮菌卻是必須在有氧條件下才能生活的好氧菌,它們是如何解決需氧但又必須防止氧傷害其固氮酶這個矛盾的呢?已知有以下一些保護固氮酶免受氧傷害的機制:
1.固氮菌保護固氮酶的機制
(1)呼吸保護
固氮菌屬的許多細菌以其較強的呼吸強度迅速耗去固氮部位周圍的氧,以使固氮酶處於無氧的微環境中而免受氧的傷害。
(2)構象保護
褐球固氮菌等有一種起著構象保護功能的蛋白質——Fe-S蛋白質Ⅱ,在氧分壓增高時,它與固氮酶結合,此時,固氮酶構象發生改變並喪失固氮活力;一旦氧濃度降低,該蛋白便自酶分子上解離,固氮酶恢復原有的構象和固氮能力。
固氮細菌2.藍細菌保護固氮酶的機制
進行產氧光合作用的藍細菌普遍有固氮能力,其具有獨特的保護固氮酶機制。
分化有異形胞的絲狀細菌在異形胞中進行固氮作用。異形胞是部分藍細菌適應於有氧條件下進行固氮作用的特殊細胞。它有很厚的細胞壁,缺乏產氧光合系統Ⅱ,有高的脫氫酶和氫化酶活力,這些特性使異形胞保持高度的無氧或還原狀態,固氮酶不會受氧的傷害。此外,異形胞還有高的超氧化物歧化酶活力,有解除氧毒害的功能;其呼吸強度也高於鄰近的營養細胞。
沒有異形胞分化的藍細菌有的將固氮作用與光合作用分開進行(黑暗下固氮,光照下進行光合作用),如織線藍細菌屬等;有的在束狀群體中央失去光合系統Ⅱ的細胞中進行固氮作用,如束毛藍細菌屬;有的則通過提高細胞內過氧化物酶或超氧化物歧化酶活力以解除氧毒害,如粘球藍細菌屬等,以保護固氮酶。
3.根瘤菌保護固氮酶的機制
與豆科植物共生的根瘤菌以類菌體形式生活在豆科植物根瘤中,根瘤不僅提供根瘤菌以良好的營養環境,還為根瘤菌固氮酶提供免受氧傷害的場所。類菌體周圍有類菌體周膜包著,膜上有一種能與氧發生可逆性結合的蛋白——豆血紅蛋白(Lb),它與氧的親合力極強,起著調節根瘤中膜內氧濃度的功能,氧濃度高時與氧結合;氧濃度低時又可釋放出氧。從而既保證了類菌體生長所需的氧,又不致對其固氮酶產生氧傷害。
非豆科植物共生根瘤菌(如共生在糙葉山麻黃根瘤中的豇豆根瘤菌)依靠非豆科植物所含的植物血紅蛋白(具有與豆血紅蛋白類似功能的蛋白)保護著固氮酶免受氧傷害。共生在赤楊、楊梅和山麻黃等非豆科植物根瘤中的弗蘭克氏屬放線菌在其營養菌絲末端膨大的球形囊——泡囊中進行固氮作用。泡囊與藍細菌的異形胞相似,有保護固氮酶免受氧傷害的功能。
套用
固氮菌將一氧化碳變燃料
丙烷是一種點燃後形成藍色火焰的氣體,全美火爐排放的氣體都含有丙烷。釩固氮酶通常可以從氮氣中生成氨。科學家警告說,這項研究尚處於早期階段,不過他們同時表示,該研究最終可能會帶來全新、環保的燃料生產方式,最終從稀薄的空氣提取汽油。參與實施這項研究的美國加州大學歐文分校科學家馬庫斯-里貝(Markus Ribbe)說:“這種微生物是一種非常常見的土壤細菌,我們對其已有深入了解,並且實施了長期的研究。”
研究結果刊登在最新一期的《科學》雜誌上。里貝補充說:“雖然我們仍在研究釩固氮酶,但我們知道這種酶具有不同尋常的特性。”科學家研究的那種微生物名叫棕色固氮菌(Azotobacter vinelandii),是一種對環境很重要的細菌,它通常存在於像大豆等固氮植物根部周圍的土壤中。
農場主之所以對含有棕色固氮菌的植物情有獨鍾,是因為這種細菌可充分利用多種酶,將大氣中毫無用途的氮氣變成重要的氨和其他化合物。接下來,其他植物吸收這些化合物,利用它們生長。里貝在研究中與合作者將一種氮——釩固氮酶——隔離出來,用以將氮變成氨。接著,他們從釩固氮酶中分離出氮和氧,並用一氧化碳填補剩餘空間。
沒有了氮和氧,釩固氮酶開始將一氧化碳變成兩到三個原子長的短碳鏈。一個三碳鏈通常被稱為丙烷,這是一種點燃後形成藍色火焰的氣體,全美的火爐都在使用。加利福尼亞理工學院的科學家喬納斯-彼得斯說,從科學上講,釩固氮酶的新功能是一項“意義深遠的發現”。
空氣變汽油還需時日
空氣變油有希望里貝說:“很顯然,如果我們可以製造出更長的碳碳鏈,這項發現最終會令我們開發出合成液態燃料。”新酶只能形成兩到三個碳鏈,而不是構成液態汽油的更長鏈。不過,里貝認為他可以對釩固氮酶做出改動,令其可以生成汽油。如果這項技術得到進一步完善,最終或能令汽車以自身排放的尾氣當作部分燃料。而經過更長時間的研究,汽車甚至還能從空氣中“吸收”二氧化碳供其運行的燃料,而目前已經擁有將二氧化碳變為一氧化碳的技術。
里貝和彼得斯均表示,在近期內還不能做到這一步。里貝說:“提取釩固氮酶的難度非常大。”由於其在農業方面的重要性,科學家很早以前就對這種酶有了了解。他們甚至在20多年前就隔離出釩固氮酶的基因,為遺傳工程師和合成生物學家深入了解這種酶創造了條件。不過,大量提取、生長和儲存釩固氮酶的技術直到近幾年才開發出來,也令這項最新研究成為可能。在開發出以空氣和細菌為燃料的汽車以前,科學家還必須實施進一步研究。